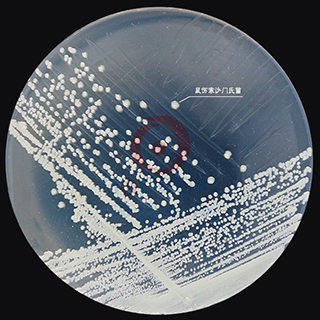
产品细节图片4
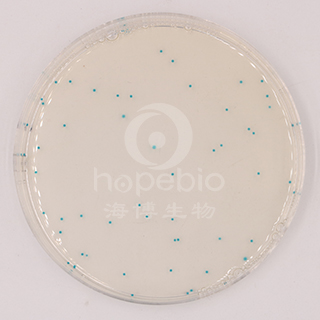
产品细节图片5
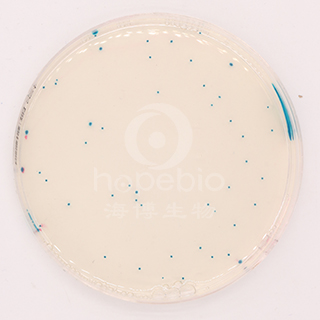
产品细节图片7

万千商家帮你免费找货
0 人在求购买到急需产品
- 详细信息
- 询价记录
- 文献和实验
- 技术资料
- 保存条件:
请置于阴凉干燥处保存
- 保质期:
二年
- 英文名:
Coliform Chromogenic Medium
- 库存:
100
- 供应商:
青岛海博生物
- 规格:
1000ml
大肠菌群显色培养基是青岛海博生物公司改良的培养基,用于食品、水、牛奶、冰激凌和肉制品中大肠菌群的快速检测。大肠菌群显蓝绿色,其它菌显黄色或无色,革兰氏阳性菌被抑制。
成份(g/L)
| 特殊营养物质 |
34.55 |
| 显色剂 |
0.35 |
| 琼脂 |
13.0 |
| pH 7.0-7.2 25℃ | |
此配方可以进行改良或增加营养成份以获得最佳的结果。
用法
称取本品 47.9g 加入 1000ml 蒸馏水,加热溶解并不停搅拌,煮沸不要超过 1 分钟。分装三角瓶,121℃ 高压灭菌 15 分钟。取 1ml 制备好的样品液加入直径为 9cm 无菌平皿中心,倾入冷却至 45-50℃ 培养基约 15ml,混匀,凝固后,36℃ 倒置培养 18~24h。
或冷却至 45-50℃ 时,倾入无菌平皿,琼脂完全凝固后,在 37℃ 的培养箱中倒置放置 1-2 小时,加入适当稀释度的样品液 1ml,涂布于培养基上,36℃ 培养 18~24h。
操作步骤
1、按国家标准、SN标准、FDA标准或其它方法制备样品液;
2、取样品液 1ml 加入冷却至 45-50℃ 显色培养基中混匀或涂布于平板上;
3、36℃ 培养 18~24 h,选用有 30~200 个菌落的平板,计数平板上出现的典型大肠菌群菌落。大肠菌群典型菌落为蓝绿色,其它细菌为无色或黄色菌落。
总大肠菌群=蓝绿色菌落;
4、对可疑大肠菌群菌落可划线接种到营养琼脂平板上,36℃ 培养 12-16 小时,挑取单菌落做大肠菌群 BGLB 发酵试验。
质量控制
1、外观
此干燥培养基的粉末均匀,具有良好的流动性,呈乳白色。制备好的平板呈透明无色固体培养基。
2、微生物试验
在 36℃ 培养 18~24h 小时:
|
质控菌株 |
ATCC |
生长情况 |
菌落颜色 |
|
单增李斯特氏菌 |
19114 |
-/+ |
无色 |
|
金黄se葡萄球菌 |
25923 |
-/+ |
无色 |
|
大肠杆菌 |
25922 |
+++ |
蓝色 |
|
沙门氏菌 |
14028 |
+++ |
无色 |
|
阴沟肠杆菌 |
23355 |
+++ |
蓝色 |
|
产气肠杆菌 |
35029 |
+++ |
蓝色 |
|
弗氏柠檬酸盐杆菌 |
43864 |
+++ |
蓝色 |
|
肺炎克雷伯氏菌 |
10031 |
+++ |
蓝色 |
方法的局限性
本培养基鉴定大肠菌群,少数情况下可能会出现假阳性,但不会出现假阴性,有时可能需做其它补充试验。
典型特征
大肠菌群典型菌落为蓝绿色,其它细菌为无色或黄色菌落。
贮存
制备好的平板应立即使用,应避免光线直接照射。干燥培养基应放置于阴暗干燥处, 保存温度 2-8℃,注意避光保存。
失效
干燥培养基超过保质期、结块和颜色变化都不能使用。
注意
此培养基仅供实验室使用。
参考文献
1、FRAMPTON, E.W., RESTAINO, L. a. BLASZKO, L.: Evaluation of -glucuronidase substrate in a 24 hour direct plating method for Escherichia coli. J. Food Protection, 51; 402-404 (1988).
2、KILIAN, M. a. BLOW, P.: Rapid diagnosis of Enterobacteriaceae. I. Detection of bacterial glycosidases. Acta Pathol. Microbiol. Scand. Sect. B 84; 245-251 (1976).
3、LE MINOR, L. a. HAMIDA, F. BEN: Advantages de la recherche de la galactosidase sur celle de la fermentation du lactose en milieu complexe dans le diagnostic bact riologique, en particulier des Enterobacteriaceae. Ann. Inst. Pasteur (Paris), 102; 267-277 (1962).
|
|
|
|
大肠菌群显色培养基 大肠埃希氏菌ATCC25922 蓝色菌落 |
大肠菌群显色培养基 混合菌种 蓝色菌落与无色菌落 |
|
|
|
|
大肠菌群显色培养基 阴沟肠杆菌ATCC23355 蓝色菌落 |
大肠菌群显色培养基 鼠伤han沙门氏菌ATCC14028 无色菌落 |
|
|
|
|
大肠菌群显色培养基 产气肠杆菌ATCC35029 蓝色菌落 |
大肠菌群显色培养基 单增李斯特氏菌ATCC27853 抑制或部分抑制,无色菌落 |
|
|
|
|
大肠菌群显色培养基 肺炎克雷伯氏菌ATCC10031 蓝色菌落 |
大肠菌群显色培养基 弗氏柠檬酸杆菌ATCC43864 蓝色菌落 |
|
| |
|
大肠菌群显色培养基 金黄se葡萄球菌ATCC25922 抑制或部分抑制,无色菌落 | |
大肠菌群显色培养基微生物灵敏度试验:
按标签用法制备培养基,接种以下质控菌株,放置36±1℃需氧培养18-24小时。
注:回收率计算时,用TSA琼脂做对照培养基。


风险提示:丁香通仅作为第三方平台,为商家信息发布提供平台空间。用户咨询产品时请注意保护个人信息及财产安全,合理判断,谨慎选购商品,商家和用户对交易行为负责。对于医疗器械类产品,请先查证核实企业经营资质和医疗器械产品注册证情况。
- 作者
- 内容
- 询问日期
文献和实验沙门菌显色培养基CHROMagar与普通培养基SS、HE的比对实验
[摘要] 目的 比对沙门菌显色培养基与普通培养基在检测腹泻便时的敏感性差异。方法 将1000份腹泻便标本增菌后接种沙门菌显色培养基简称(CAS)和SS、HE沙门菌普通培养基做比对试验。结果 沙门菌在CAS平板上呈现特定型的红色菌落,非沙门菌呈现蓝色或无色菌落。1000份腹泻便标本中CAS阳性检出率为1.6%,高于SS阳性检出率1.5%和HE阳性检出率1.4%。结论 采用CAS选择性平板分离沙门菌较易鉴别且直观,同时也可以克服因肉眼挑选带来的主观误差,本次试验
作者:张淑红,吴清平,张菊梅 作者单位:广东环凯微生物科技有限公司,广州510070;2.广东省微生物研究所广东省菌种保藏与应用重点实验室,广州510070 [摘要] 目的:研究显色培养基对单核细胞增生李斯特菌的检测效果,探讨建立新型快速检测方法。方法:检测按国标GB4789—33程序进行。结果:人工污染样品和实际样品检测中,显色培养基CHROMagar Listeria和HKListeria与传统平板OXA和MMA可以达到相同的检测限和灵敏度,且具有更高
一、实验目的和内容 目的:学习检测水中大肠菌群的方法,了解大肠菌群数量与水质状况的关系。 内容:1.用滤膜法检测大肠菌群。 2.用多管发酵法检测大肠菌群。 二、实验材料和用具 复红亚硫酸钠培养基(远藤氏培养基)、乳糖蛋白胨半固体培养基、乳糖蛋白胨培养液、三倍浓乳糖蛋白胨培养液、伊红美蓝培养基(EMB 培养基)。 微孔滤膜(孔径0.45µm)、滤器(容量500mL)、抽气设备、镊子、发酵用试管、杜氏小管、培养皿、刻度吸管或移液管、接种环、酒精灯。 三、操作
技术资料暂无技术资料 索取技术资料